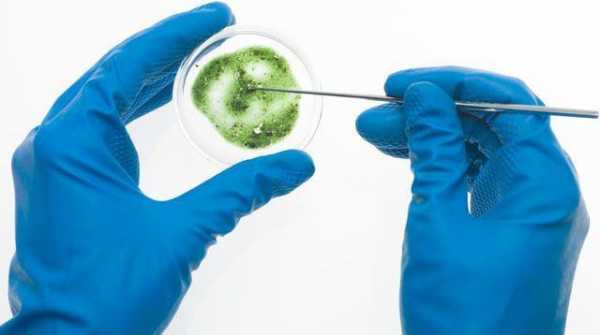

Может ли лишай пройти сам собой и какие виды требуют лечения?
Лишай может пройти сам в единичных случаях, при этом излечение будет проходить в течение длительного времени. Этот недуг требует обязательного комплексного лечения. Провоцировать усугубление заболевания могут чрезмерные физические нагрузки, стресс, посещение бани. Особой диеты в этот период не требуется, но все же следует ограничить себя в употреблении острой, кислой и соленой пищи.
ВАЖНО ЗНАТЬ! Даже «запущенный» грибок можно вывести дома, без операций и больниц. Просто прочитайте что сделала Надежда читать рекомендацию…

Что такое лишай?
Одним из самых распространенных кожных инфекционных заболеваний есть лишай. Заражение бывает от животных, людей, предметы их обихода. Болеют в основном дети и люди с ослабленной иммунной системой. При этом недуге меняется цвет кожи, она шелушится, возникает зуд и жжение пораженных участков, волосы ломаются. Как только появились аналогичные симптомы, необходимо установить истинный диагноз: выяснить вид лишая и исключить другие болезни со схожими симптомами. Важно, чтобы болезнь не перешла в хроническую форму. Есть разные ее виды. Одни из них проходят самостоятельно, а другие требуют обязательной терапии и особого ухода.
Вернуться к оглавлениюЛишай проходит, если начать своевременное лечение.
Какие виды лишая могут пройти самостоятельно?
Лишай Жибера (розовый) — вирусно-аллергическое заболевание, которым чаще болеют женщины в осенний и весенний периоды. Вызывают его: переохлаждение, авитаминоз, снижение иммунной защиты организма. Его симптомами являются пятна розового и светло-коричневого цвета, которые появляются обычно после простудного заболевания. А также в центре пятна желтеют, сморщиваются и слегка шелушатся. В большинстве случаев лечение розового лишая не проводится. При этом недуг проходит самостоятельно в течение 1—2 месяцев. Во избежание побочных эффектов используются мази для снятия зуда и антигистаминные препараты.
Вернуться к оглавлениюВиды лишая, что требуют обязательного лечения
Стригущий лишай
Все виды лишая требуют обязательного лечения, кроме розового лишая Жибера.Вызывается грибками — микроспорией и трихофитией. Выздоровление длится около 3 месяцев. Лишай проходит, если изолировать больного. При этом используются мази, кремы и растворы для местного применения, и проводится общее восстановление иммунной системы. При заболевании стригущий лишай поражается кожный и волосяной покровы, изредка ресницы и ногти.
Первыми признаками есть:
- появление красных пятен с нечеткими контурами и их припухлость, ослабевание и ломкость волос;
- увеличение площади поражения в размерах и их зуд;
- появление гнойных пузырьков.
Отрубевидный лишай
Грибковое заболевание, которое тяжело поддается излечению, иногда длится годами. Для местной терапии применяют противогрибковые средства. Признаками являются:
- на спине, шее или животе появляются пятна желто-коричневого цвета различных форм, с неровными границами;
- высыпания распространяются по поверхности кожи и шелушатся.
Опоясывающий лишай
При опоясывающем лишае может присутствовать головная боль.Вирусное заболевание. Выздоровление наступает спустя 3 или 4 недели ежедневной терапии. У пациентов старше 50 лет лечение длится довольно длительно. Большой риск заболеть у людей, не болевших ветрянкой в детстве. Для терапии используют противовирусные лекарства, жаропонижающие и анальгетики. Начальными симптомами являются:
- головная боль, повышение температуры и озноб;
- появление розовых пятен на концах нервных окончаний, которые зудят;
- корочки на пятнах.
Красный плоский
Инфекционное заболевание кожи и ногтей. Склонны к этой болезни женщины 40—60 лет. Сроки выздоровления от 6 до 18 месяцев. Для лечения принимают антигистаминные препараты на основе кортикостероидов, иммуномодуляторы и поливитамины. При недомогании повялются следующие признаки:
- на коже живота, сгибах конечностей появляются множество небольших крепких и плоских холмиков красного цвета;
- на месте травм кожи бугорки соединяются в более крупные;
- болезнь сопровождается дерматологическим зудом.
При подозрении об этом заболевании нужно обратиться к врачу-дерматологу. Он проведет диагностические обследования, определит диагноз и назначит соответствующую комплексною лечебную терапию. А также могут понадобиться консультации у других специалистов. Нужно выполнить все медицинские предписания и недуг обязательно пройдет.
etogribok.ru
Лишай на теле человека — избавляемся просто, спокойно и быстро
Одним из микозных (грибковых) поражений кожи является лишай на теле человека. Возбудителем выступают три основных вида грибов:
- Зооантропофильные, поражают как человека, так и животных. Наиболее агрессивный вид гриба по способу его распространения и передачи. Инкубационный период длится менее 3-х дней, после инфицирования.
- Антропофильные, распространяются только на коже человека. Инфекционная группа, но заражение происходит в редких случаях. Данные грибы начинают развиваться в период понижения иммунитета человека.
- Геофильные, данная группа имеет местом своего природного обитания землю, растительность и пр. Поражают человека достаточно редко, в период спада иммунной защиты.

В зависимости от вида микоза поражаются разные участки кожи, в том числе волосы и ногти. Внешние проявления и формы лишая разнятся. При медикаментозном лечении используются различные противогрибковые препараты, с агрессивным воздействием на конкретный возбудитель, и щадящие по отношению к биофлоре человека.
Микроспория — грибковое поражение головы
Наиболее распространенным поражением волосяной части головы является стригущий лишай, который поражает не только волосистый покров, но и быстро распространяется по всему телу с поражением ногтей. Заразится этой формой гриба (микроспорум, трихофитум) возможно:
- От зараженного животного или человека.
- Через предметы домашнего обихода (полотенца, расчески и пр.)
- Соприкоснувшись на улице, через одежду.
- В общественном транспорте.

Чаще всего лишай на голове появляется у детей, поскольку детская кожа более восприимчива к микозам из-за малой кислотной защиты внешних тканей. Переносчиками инфекции становятся бродячие коты, реже собаки. В 50% случаев, на теле животного, переносчика болезни, не заметны признаки лишая.
Признаки заболевания
- Появление очага круглой формы (чаще всего на границе роста волос). Центр обычно белесый, в процессе развития сереет, покрывается чешуйками. Обрамление из валика светло-розового или красного цвета.
- Зуд на месте поражения, иногда значительный.
- Обламывание волос на пораженном участке головы происходит на 2-5 день после инфицирования. Четко видны проплешины.
Применяемое лечение
Стригущий лишай на голове вылечивается в течение 3-4 недель. При значительном поражении, когда инфицированы глубокие слои кожи с появлением гнойных ран, для полного выздоровления требуется до 3 месяцев. Необходимые процедуры:
- Пораженное место волосистой части сбривается, наносится соответствующая противомикозная лекарственная форма, мази:
- Серносалициловая
- Никосептин
- Микогель
- Клотримазол и др.
- При запущенных формах заболевания могут назначаться таблетированные формы антимикозных препаратов.
Совет! При обработке головы шампунем, пораженный участок следует хорошо очистить мягкой зубной щеткой.
- Йодный 2-5% раствор наносят раз в сутки на пораженное место.
- Рекомендуется 1 раз в день проводить антисептические процедуры. Протирать пораженную поверхность головы 0,02% спиртовым раствором Хлоргексидина Биглюконат. При запущенной форме заболевания, когда появляются гнойные высыпания, спиртовой раствор заменяют водным 0,05% раствором данного препарата.
- Грибок погибает при высокой температуре и в кислой среде. Поэтому все белье стирается в горячей воде, хорошо полощется в уксусе и интенсивно гладится.
Лишай на глазах обрабатывается щадящими препаратами, без использования йода, с полным или частичным удалением бровей и ресниц.
При лечении лишая на веках не рекомендуется использовать спиртовые растворы и йод. Дополнительное раздражение слизистой глаза может спровоцировать развитие коньюктивитов.
Поражение ног и ступней
Во время отдыха в незнакомом месте или при купании в водоеме может произойти заражение геофильными грибами. В таких случаях на 2-5 день человек обнаруживает лишай на ступне. Это может быть как заражение трихоспорумом (стригущий лишай), так и другой, менее агрессивной формой гриба, например липофильным дрожжевым грибом (цветной).

Цветной или отрубиевидный лишай в основном поражает верхний слой кожи ног, щиколотки. Заражение внешними носителями происходит редко, в отличие от стригущего лишая, он практически не передается от человека к человеку.
Сложность лечения обусловлена тем, что ступни постоянно соприкасаются с поверхностью обуви, все лекарственные формы интенсивно работают только ночью, в относительном покое .
Применяемое лечение при лишае на ногах
- Полная дезинфекция всей обуви. Все, что можно стирать — выстирать в горячей воде. лучше выварить. Полоскать в уксусе.
- Внутреннюю поверхность обуви обработать спиртом.
- Исключить синтетические носки, колготы и пр.
- Применять утром и днем противомикозные препараты, как и в случае поражения головы, на ночь смазывать ступни йодом.
Совет! Поскольку кожа ступни достаточно плотная можно использовать смолу после сожженной газеты. Врачи не рекомендуют данное средство, т.к. смола достаточно токсичное соединение. Наряду с грибковыми спорами (любой формы) она убивает всю флору, и производит ожег кожи. Практика же показывает, что при поражении стоп этот варварский метод хорошо работает. Выбор за пациентом.
Лишайные поражения спины
Одна из разновидностей кожных поражений — это розовый лишай на спине. Не смотря на то, что данное заболевание является инфекционным, и может поразить все тело, розовый лишай у человека
не передается при бытовых контактах, через одежду и т.д. 
Точная причина данного заболевания не выявлена. Существует несколько медицинских предположений:
- Как следствие после перенесенных вирусных заболеваний.
- Предположительным источником лишая на теле может быть вирус герпеса 7 типа.
- Стрессы.
- Общее понижение иммунитета.
Признаки заболевания
На теле, в 90% случаях на спине появляется красное пятно диаметром 1-2 см. В течение месяца появляются высыпания, в виде красных, розовых, реже желтых небольших водяных прыщей, которые распространяются по туловищу от первичного очага.
При возникновении лишая на губе, его часто путают с классическим герпесом, поскольку форма и симптоматика одинаковы.
Симптомы, сопровождающие заболевание
- Незначительное повышение температуры.
- Общая слабость.
- Появление нестандартных аллергических реакций на еду.
Применяемое лечение
Препараты для лечения розового лишая имеют щадящий эффект, поскольку данное поражение является следствием сбоя в работе иммунной системы. Обязательным является диагностика у врача инфекциониста на предмет определения вирусной нагрузки на организм.
- Используются успокаивающие мази на основе салициловой кислоты, поскольку очаги поражения могут зудеть.
- Ванны с настойкой череды и ромашки.
- Употребление витаминных комплексов с высоким содержанием кальция, витамина С и витамин группы В.
Грибковое поражение шеи
Чаще всего стригущий лишай на шее появляется через заражение одежды. Если ребенок примерял чужой шарф и пр. В этом случае распространение инфекции поразит голову и лицо. Розовый и цветной лишай поражает тело бессистемно, шея наименее подвержена таким формам гриба.

Стригущий лишай на лице
и шее характерен очагами светло розового цвета, с шелушащейся серединой и уплотнением цвета по краям.При стандартной терапии на область лица и шеи не рекомендуется наносить йод, и не использовать народные средства, которые причиняют ожоги (сок чистотела, смола).
Совет! Как дополнительный метод к медикаментозному лечению пораженную область на шее протирают соком чеснока два раза в день.
При запущенных стадиях грибкового заболевания, инфекция поражает глубокие ткани, появляются гнойничковые раны, в очагах часто наблюдают развитие стрептококковых агентов.
При лечении шейного отдела применяют противомикозные препараты:
- Ламикон.
- Фуцис.
- Антимикоточеские спреи.
- Применяют протирание пораженного участка борной, салициловой кислотой.
Еще один вид грибкового поражения – это цветной (отрубиевидный) лишай, который поражает плечи, шею, верхнюю часть груди и спины.
Данное заболевание не носит инфекционного компонента. Развивается у людей в возрасте от 16 до 45 лет.
Клинические проявления цветного лишая
- Появление разноцветных пятен, от желтого до бурого, с неровными краями очага.
- Возможен зуд на месте появления.
Данный вид грибкового поражения связан с такими факторами:
- Нарушение иммунной функции организма.
- Возможен как указывающий сигнал на скрытые заболевания, такие как туберкулез, сахарный диабет и прочие
- Нарушением кислотного баланса в верхних слоях эпидермиса.
- Процесс регенерации кожи происходит с нарушениями.
Совет! Обнаружить скрытые формы данного лишая можно после загара. Тщательно осмотреть тело на предмет появления белых пятен. Грибок вырабатывает азолоиновую кислоту, которая обесцвечивает меланин – природный пигмент кожи.
Применяемое лечение
Поскольку данный вид гриба живет на коже любого человека, и быстро развивается при потоотделение, рекомендуется:
- Принимать душ 2-3 раза в день.
- Обрабатывать пораженное место шеи 2-5% раствором салициловой кислоты.
- Наносить на ночь противогрибковые препараты на основе салицила.
Поскольку отрубиевидный лишай это всегда следствие, то обязательным является сдача общего анализа крови и осмотр у врача инфекциониста.
Грибковое поражение живота.
Чаще всего стригущий лишай на животе обнаруживается у детей младшего школьного возраста. Люди в возрасте от 17 лет подвержены розовому и отрубиевидному поражению живота. Наиболее уязвимыми для данного гриба являются бока, середина живота. Розовый лишай под мышками причиняет наибольшее беспокойство. В данной области расположено наибольшее количество потовых желез. Выделяемый пот всегда идеальная пища для любого вида гриба.

Клинические проявления стригущего лишая на животе.
- Появление характерных пятен. В данной области они имеют чаще всего ярко красный цвет первые 2-5 дней, затем бледнеют, начинается процесс шелушения.
- Особенно сильный зуд, поскольку кожа живота имеет достаточное количество потовых желез.
- Лечение в данной области ничем не отличается от лечения лишая на голове. Применяются те же противогрибковые препараты, дополнительно можно использовать сок чеснока для протирания пораженного участка 2 раза в день.
Важно! В районе живота нельзя применять народное средство на основе газетной смолы. Это причинит значительный ожег и уничтожит местный иммунитет.
Лишайные поражения лобковой области
Паховую область при поражении любым видом грибка рекомендуется обработать 0,02% водным раствором Хлоргексидина Биглюконат. Этот антисептик обеззаразит участок кожи, которую рекомендуется аккуратно избавить от волосяного покрова. Волосы рекомендуют коротко состричь, не брить.

Стригущий лишай на лобке имеет ту же природу, что и на любом другом участке тела, поэтому лечение кардинально не отличается от предыдущих схем. Существуют некоторые нюансы при лечении лишая на половых губах:
- Не использовать обычные противогрибковые препараты для обработки влагалища. Смазывать только внешнюю кожу на больших губах. Для лечения слизистых оболочек использовать антимикозные свечи.
- Отказаться от стрингов. Носить только белье из натуральных материалов.
- Применять орошение лобка (как мужчинам, так и женщинам) 0,02% водным раствором Хлоргексидина.
Совет! В период лечения отказаться от половых контактов, поскольку грибок стригущего лишая способен поражать глубокие слои кожи и слизистых.
Грибковое поражение полового члена
При поражении члена агрессивной, заразной формой лишая рекомендуется использовать препараты, для обработки внешней поверхности:
- Микогель
- Ламикон
- Ламизил
Розовый и отрубиевидный лишай на члене практически не появляется.
Применяемое лечение при поражении стригущим лишаем
- Обрабатывать член 0,02% водным растворам Хлоргексидина 1 раз в день.
- Наносить противомикозную мазь 2-3 раза в день.
- После посещения туалета желательно обработать орган настойкой из ромашки или 2% раствором салициловой кислоты. Это снимет зуд, который в районе члена особенно силен.
Курс лечения при средней форме продолжается около 3-х недель.
Поскольку грибы сопровождают человека с первой секунды жизни, нужно иметь полную информацию для своевременного предотвращения вирусных атак и ответственно подходить к своему здоровью.
kozhainfo.ru
виды, симптомы, лечение у человека
 Существует масса заболеваний, которым подвергается кожа человека. К числу наиболее распространенных заболеваний относится лишай. Это серьезная дерматологическая проблема, с которой сталкиваются многие люди. Под данным термином следует понимать целый ряд поражений кожи, которые довольно заразны. Основным способом их распространения является контактно-бытовой путь.
Существует масса заболеваний, которым подвергается кожа человека. К числу наиболее распространенных заболеваний относится лишай. Это серьезная дерматологическая проблема, с которой сталкиваются многие люди. Под данным термином следует понимать целый ряд поражений кожи, которые довольно заразны. Основным способом их распространения является контактно-бытовой путь.
Большинство разновидностей лишая имеют грибковую природу или возникают при инфицировании человека вирусом. Их отличает длительность протекания. Если при возникновении лишая помощь будет оказана несвоевременно, то это может привести к обострению патологических процессов. Следствием этого может стать возникновение некроза пораженных тканей. Люди, далекие от медицины, слабо осведомлены о причинах возникновения этого заболевания и способах его лечения. Поэтому в этой статье будет подробно изложена эта важная информация.
Этимология заболевания
 Вирусы, грибки являются основными возбудителями, приводящими к возникновению на коже этого заболевания. Вероятность его появления увеличивается под воздействием неблагоприятных факторов. К числу таковых относятся:
Вирусы, грибки являются основными возбудителями, приводящими к возникновению на коже этого заболевания. Вероятность его появления увеличивается под воздействием неблагоприятных факторов. К числу таковых относятся:
- снижение иммунитета;
- частые стрессовые ситуации;
- инфекционные поражения;
- значительные физические и эмоциональные нагрузки.
Кроме того, отметим, что к числу факторов относится и генетическая предрасположенность.
В зависимости от факторов, которые приводят к возникновению этого заболевания, выделяют следующие разновидности лишая.
Розовый лишай. Возбудитель этой разновидности заболевания до сих пор четко не идентифицирован. Специалисты говорят о том, что эта форма болезни возникает в тех случаях, когда у человека снижается иммунитет на фоне перенесенного гриппа или ОРВИ.
Стригущий лишай. Его вызывает гриб трихофитон. Чаще всего он возникает у детей.
Псориаз. Развитие этой разновидности лишая происходит при возникновении иммунологических изменений в организме человека, которые в большинстве случаев имеют генетическую природу. Стресс является наиболее серьезным этиологическим фактором. Кроме него, есть и другие факторы, которые могут приводить к возникновению этого заболевания:
- воздействие на кожу химических веществ;
- химиотерапия;
- чрезмерное употребление алкогольных напитков.
Если не избегать этих факторов, то высок риск возникновения на коже такой разновидности лишая. Также отметим, что при их наличии трудно побороть болезнь, поскольку для псориаза характерно частое возникновение рецидивов.
Опоясывающий лишай. Его провоцирует вирус группы Herpes zoster. Эта болезнь может развиваться при возникновении у человека герпетической инфекции, которая скрытным образом может протекать в организме.
Трубчатый лишай. Его диагностируют, когда в чрезмерно большом количестве начинают размножаться грибки, которых причисляют к нормальной микрофлоре кожи человека. Увеличение колоний грибка происходит при:
- снижении защитных свойств иммунной системы человека;
- слишком большом выделении секрета потовыми железами.
В медицинской практике известны случаи, когда это заболевание передавалось по наследству.
Красный плоский лишай. Специалистам до сих пор неизвестен возбудитель этого заболевания. Высказывается предположение, что основной причиной, приводящей к возникновению этого заболевания, может быть склонность больного к аллергии, частые стрессы и вирусные инфекции. Чаще всего этим заболеванием страдают люди, у которых есть сахарный диабет или имеются патологии органов пищеварительной системы.
Из приведенного выше перечня видно, что разновидностей лишая достаточно много. У каждой кожной болезни имеется своя этиология, поэтому и терапия при избавлении от недуга может быть различной.
Специалисты выделяют также еще два вида этой болезни — мокнущий и сухой лишай. Под сухим принято понимать такое поражение кожи, причиной возникновения которого является инфицирование В-гемолитическим стрептококком. Это заболевание имеет другое название — сухая пиодермия.
Мокнущий лишай от других видов и разновидностей этой болезни отличается тем, что представляет собой воспалительное поражение кожи в хронической форме. Он является заразным, и природа его возникновения аллергическая. Часто эту патологию специалисты называют экземой. Причины, приводящие к его появлению у человека, следующие:
- наследственность;
- нарушения в работе печени.
Способствует возникновению этого заболевания наличие у больного вегетососудистой дистонии, а также эндокринных патологий. Воздействие внешних факторов – холода, использование косметики и моющих средств, раздражение кожи одеждой невысокого качества также способствует появлению этого заболевания.
Симптомы различных видов лишая
Как было сказано выше, существует несколько разновидностей лишая, и у каждой болезни есть свои симптомы, по которым можно диагностировать заболевание.
Розовый лишай
 Перед возникновением этого заболевания больные высказывают жалобы на головную боль и артралгию. Одним из первых признаков этого вида лишая является увеличение периферических лимфоузлов. После этого по всему телу появляются розовые пятна небольшого размера. По мере прогрессирования заболевания пятна разрастаются и увеличиваются в размерах. В отдельных случаях пятна возникают не только на туловище, но и на коже конечностей и шеи. Редко при розовом лишае пятна могут локализоваться на лице.
Перед возникновением этого заболевания больные высказывают жалобы на головную боль и артралгию. Одним из первых признаков этого вида лишая является увеличение периферических лимфоузлов. После этого по всему телу появляются розовые пятна небольшого размера. По мере прогрессирования заболевания пятна разрастаются и увеличиваются в размерах. В отдельных случаях пятна возникают не только на туловище, но и на коже конечностей и шеи. Редко при розовом лишае пятна могут локализоваться на лице.
Довольно часто высыпания сопровождаются появлением зуда. По прошествии нескольких дней центр пятен западает и меняет свой цвет на бурый оттенок, а кроме этого покрывается чешуйками. Происходит подниятие краев высыпаний. Розовый оттенок сохраняют пятна по периферии. Эти элементы розового лишая называют медальонами. Необходимо отметить, что при возникновении этого заболевания сначала появляется материнские пятно, а потом возникают дочерние, которые имеют более мелкий размер.
Стригущий лишай
Эта разновидность лишая может возникать на практически любом участке тела человека. Часто он появляется на ногтях, а также на волосяном покрове головы. Если на коже происходит локализация сыпи, то распознать это заболевание можно по пятнам, которые слегка набухшие, имеют округлую форму. Они окружены каймой из пузырьков и корочек. В их центральной части имеется незначительное отшелушивание.
Если пятна появились на голове, то они имеют вид многочисленных плешин, которые покрыты чешуйками серо-белого цвета. Особенность лишая этого вида заключается в том, что при возникновении пятен на голове волосы в местах их образования не выпадают, но обламываются. Их длина уменьшается, и над уровнем кожи они выступают всего на 2-3 мм.
Псориаз
Красные пятна, которые приводят к сильному зуду и сопровождаются шелушением — основное проявление этой разновидности лишая. Чаще всего они появляются на волосистой части головы, а также на лице. Нередко они локализуются в области коленей и локтей. Также пятна могут появляться на спине и в складках кожи. Иногда при псориазе поражаются ногти.
Опоясывающий лишай
Для этого заболевания характерны продромальные признаки в виде недомогания, повышенной температуры и слабости. Иногда при этой болезни человек испытывает чувство тошноты, у него появляется рвота. У этого заболевания инкубационный период может составлять несколько лет. Вначале появляется парестезия, а также боли в области будущей сыпи. По прошествии нескольких дней возникает отек и гиперемия.
После этого появляются папулы, которые позднее превращаются в пузырьки, имеющие прозрачное содержимое. Подсыхание пузырей происходит на 8 день. Затем образуются корочки. На груди и в межреберных промежутках обычно локализуется сыпь. Однако поражаться могут слизистые рта, глаз, влагалища. Если заболевание имеет атипичное течение, то возникающий болевой синдром не имеет сыпи.
Основная опасность лишая этого вида заключается в том, что он может поражать нервные ганглии. В самых тяжелых случаях этого заболевания допускается появление атаксии, галлюцинаций, порезов. Особую опасность эта разновидность лишая представляет для беременных. Если в первом триместре произошло инфицирование женщины, то у ребенка могут возникнуть проблемы с глазами, появиться гипоплазия конечностей. Также это заболевание может привести к замедленному психомоторному развитию ребенка. Инфицирование беременной на конечных сроках беременности приводит:
- к преждевременным родам;
- к повышению риска рождения мертвого ребенка.
Плоский красный лишай
Первым признаком лишая этого вида является появление точечной сыпи красного цвета, которая сопровождается возникновением зуда и шелушения. По мере дальнейшего развития болезни сыпь меняет окраску и приобретает сине-фиолетовый оттенок. На месте появления сыпи после излечения остаются пигментные пятна темного цвета. Иногда при этой болезни возникают уплотнения кожи. Если заболевание протекает в генерализованной форме, то этот недуг может длиться годами и поражать всю кожу.
Если вы не знаете точно, что у вас на коже — обычная бородавка или лишай, признаки лишая помогут вам поставить точный диагноз. Однако все лучше, если вы доверите его постановку врачу.
Как вылечить болезнь в короткие сроки?
Терапия при возникновении этого заболевания во многом зависит от природы лишая и интенсивности его клинических проявлений. Многие люди, столкнувшиеся с лишаем, задаются вопросом, можно ли купаться, когда на руке имеется участок пораженной кожи. Однозначный ответ на этот вопрос дать довольно сложно. Все дело в том, что это заболевание имеет значительную продолжительность.
При этом без гигиенических процедур просто не обойтись. Специалисты больным, страдающим от лишая, рекомендуют принимать не ванну, а душ. Допустимым является использование косметических средств с пометкой гипоаллергенно. Также при этом заболевании можно пользоваться моющими средствами, обладающими противогрибковым действием. Частоту, с которой должны проводиться гигиенические процедуры, указывает врач-дерматолог.
Какой-то специфической терапии для лечения розового лишая нет, поскольку он может самостоятельно проходить по прошествии нескольких недель. А для того чтобы избежать длительного лечения этого заболевания, необходимо не допускать раздражения одеждой участков кожи, которые поражены лишаем. Если возникает сильный пот, то следует принимать антигистаминные лекарства. Использование гормональных мазей и кремов при лишае не практикуется.
Заключение
Многие люди в наше время страдают от кожных заболеваний. Одним из самых распространенных является лишай. Каждый человек, который столкнулся с такой проблемой, конечно же, хочет побыстрее избавиться от нее. Для этого не нужно заниматься самолечением.
Обнаружив пятна на своем теле, необходимо обратиться к врачу-дерматологу. Он проведет осмотр, поставит диагноз и назначит соответствующее лечение. Точное соблюдение рекомендаций доктора и прием назначенных препаратов позволят ускорить исцеление и избежать неприятных последствий, как для кожи, так и для организма в целом.
dermatolog.guru
Лишай: Виды, симптомы, лечение — Сыпи(высыпания)
Лишай – это шелушащиеся пятна или папулы на слизистых оболочках или коже. Вирус, грибок, инфекция и аллергия могут спровоцировать появление лишая, который чаще всего возникает на фоне гормональных или эндокринных нарушений, а также ослабленного иммунитета.
Виды лишая
Существует огромное количество видов лишая: розовый, стригущий, красный плоский, тропический белы и черный, простой, чешуйчатый, опоясывающий, отрубевидный и так далее.
Розовый лишай проявляет себя появлением пары пятен аналогичного цвета на коже. Через несколько дней от этих материнских бляшек начинают отходить мелкие розовые пятна, не вызывающие зуда. При правильном лечении через девять недель сыпь проходит.
Стригущий лишай появляется на волосистой части головы и на теле. Шелушащиеся пятна обламывают волосы в зоне поражения, у человека появляются проплешины. На коже лишай немного возвышается. Редко лишай поражает ногти, которые начинают крошиться и желтеть.
Красный плоский лишай – это розово-фиолетовая мелкая сыпь, появляющаяся на груди, животе, пояснице и конечностях. Сыпь образует рисунок и сильно зудит.
Виды лишая можно перечислять до бесконечности. Человеку без медицинского образования данная информация ничего не даст. Лучше сходит к дерматологу, и начать правильное лечение.
Розовый лишай
Из вирусов или аллергенов может образоваться розовый лишай. Шелушащиеся пятна поражают туловище, конечности и шею. Происходит это в основном в межсезонье, когда люди чаще всего простужаются.
Лишай появляется у людей с ослабленным иммунитетом. Если человек переохладился или постоянно простывает, у него лишаи возникают регулярно.
Вначале появляется материнская бляшка – пятно диаметром в два сантиметра с четкими краями. В центре пятно желтое. Постепенно центральная часть сморщивается и шелушится. При этом человек испытывает головную боль, слабость и общее недомогание. Дня через четыре на коже появляется большое количество пятен.
Через месяц или два сыпь проходит. Причем лечить её, совсем не обязательно, пятна исчезают самостоятельно. Некоторые не хотят ждать столько времени и начинают активно лечиться. Во время лечения запрещается частое мытье. Принимать душ нужно с мягкими моющими средствами. Переохлаждаться и загорать нельзя. Дерматологи обычно прописывают антибиотики, болтушки из водно-спиртовых или масляных растворов, мази с глюкокортикостероидами, травяные настои, противоаллергические препараты и витамины.
Опоясывающий лишай
Опоясывающий лишай возникает из-за вируса ветряной оспы. Если человек в детстве переболел ветрянкой, возбудитель заболевания переходит в латентное состояние и живет нервных клетках спинного мозга или в ганглиях автономной нервной системы.
Опоясывающий лишай – это медленно протекающее и возвратное заболевание, которое чаще всего возникает у людей с ослабленным иммунитетом в возрасте от 60 до 75 лет. Также в группе риска находятся люди, которые постоянно испытывают стресс, у которых есть опухоли и больные ВИЧ.
У пациента вначале поднимается температура, появляются зуд и недомогание. Через некоторое время тело покрывается пятнами, которые через несколько дней превращаются в эритематозные папулы.
Опоясывающий лишай имеет несколько разновидностей: офтальмический опоясывающий герпес, синдром Рамсея-Ханта и двигательный опоясывающий герпес. Офтальмический опоясывающий герпес повреждает роговицу и глазную ветвь тройничного нерва. При синдроме Рамсея-Ханта парализует мимическую мускулатуру, высыпания возникают в наружном слуховом проходе и в ротоглотке. Человек начинает хуже слышать, его мучают головокружения и боли в слуховом проходе. Двигательный опоясывающий герпес проявляет себя мышечной слабостью и сыпью.
Опоясывающий лишай лечится такими препаратами, как «Фамцикловир», «Ацикловир» и «Валацикловир». «Ацикловир» встраивается в вирусную молекулу ДНК и не дает ей размножаться. Если начать использовать эти препараты сразу же после появления первых признаков опоясывающего лишая или хотя бы в первые три дня, болезнь закончится намного быстрее, боль исчезнет, а вероятность возникновения постгерпетической невралгии будет равна нулю. Для того чтобы пациент мог нормально двигаться и дышать, ему назначают наркотические анальгетики. Можно использовать и ненаркотические анальгетики: «Декскетопрофен», «Напроксен», «Ибупрофен», «Кеторолак» и другие.
Кортикостероидные препараты уменьшают зуд и воспаление, но их не советуют использовать при лечении данного заболевания.
Красный плоский лишай
Этот вид лишая поражает не только ногти и кожу, но и слизистые оболочки. Зудящая сыпь появляется на животе, спине и сгибательных поверхностях.
Красный плоский лишай может появиться, как из-за вирусов, так и из-за аллергенов. Были случаи, когда люди покрывались красным лишаем из-за стресса.
Вначале у человека появляются блестящие мелкие папулы диаметром в пять миллиметров, которые постепенно сливаются и образуют сплошное пятно, похожее на сетку. Если смазать кожу растительным маслом, будет хорошо видна эта сетка. Центральная часть розово-фиолетового узелка немного вдавлена. После исчезновения сыпи, на коже остаются коричневые пятна.
Нередко сыпь появляется во рту, на половых губах и головке пениса. Здесь лишай напоминает бородавки светло-серого цвета. Красный плоский лишай бывает линейный, атрофический, гипертрофический, буллезный, приплюснутый, кольцевидный, пигментный и эритематозный.
При атрофическом лишае в месте высыпаний кожа отмирает. Линейный лишай образуется по ходу нервов. Гипертрофический или бородавчатый лишай представляет собой фиолетовую или синюю сыпь, которая похожа на бородавки. После длительного приема лекарственных препаратов может появиться буллезный лишай. Если лишай имеет вид колец или дуг, которые быстро охватывают новые участки, его называют кольцевидным.
Красный плоский лишай может появиться на ногтях. Ногтевые пластины мутнеют, источаются, становятся ломкими и бугристыми.
Стригущий лишай
Данный вид лишая является инфекционным заболеванием, которое чаще всего возникает у детей, животных и людей среднего возраста. Заражение происходит при непосредственном контакте с больным животным или человеком. Стригущий лишай появляется на теле, конечностях и волосистой части головы. Самое ужасное в этом виде лишая то, что на голове появляются проплешины. Для того чтобы избавиться от лишая на голове, надо состричь все волосы. Это ужасно, особенно в подростковом возрасте. Детям сложно объяснить, что лишай – это такая же болезнь, как и другие. Становиться предметом насмешек, никому не хочется.
Разноцветный лишай
Разноцветный лишай – это грибковое заболевание кожи, при котором поражается роговой слой эпидермиса. Возбудитель поселяется в роговом слое эпидермиса и в устьях фолликулов.
Этим видом лишая заражаются люди с сахарным диабетом, вегетоневрозом, туберкулезом и повышенной потливостью.
Лечится такой лишай жидкостью Андриасяна, мазью Вилькинсона и салицилово-резорциновым спиртом. Главное в лечении – ускорить отшелушивание рогового эпидермиса.
Лишай причины
Грибковая и вирусная микрофлора провоцирует появление лишая. Он возникает у тех, кто часто находится в стрессовых ситуациях. Лишай причины могут быть в генетической предрасположенности, слабом иммунитете, инфекционных заболеваниях, эмоциональных и физических перенапряжениях. Сколько времени длится заболевание, сказать сложно, все зависит от индивидуальных особенностей человека и вида лишая.

Лишай лечение
Некоторые виды лишая не требуют специфического лечения. Например, розовый лишай через 4-7 недель проходит самостоятельно. Дерматологи нередко назначают антигистаминные препараты («Тавегил», «Зиртек», «Лоратидин»). Во время лечения рекомендуется как можно реже мыться, при этом не использовать никакие косметические средства.
Стригущий лишай лечение заключается в изоляции пациента и обработке пораженных участков. Тех, кто болеет стригущим лишаем, госпитализируют и сбривают им волосы на голове. Каждое утро пятна смазывают йодом, а на ночь наносят серно-дегтярную или серно-салициловую мазь. Врач прописывает противогрибковые препараты.
Мазь от лишая
Отрубевидный и стригущий лишаи возникают из-за грибковых агентов, для того чтобы от них избавиться нужно провести местную и системную противогрибковые терапии. В данной ситуации назначают «Тербинафин», «Кетоконазол» или «Итраконазол» в таблетках. Салициловая кислота с серой или серно-салициловая мазь обладает противомикробным действием и убивает паразитов. Мазь от лишая серно-дегтярная оказывает дезинфицирующее и местнораздражающее действие.
Утром лишай обрабатывается йодом, а вечером – мазью. Лечение длится около трех недель.
Есть ещё мыло, паста и шампунь «Сульсен». Этот препарат используют при дерматомикозах: себорейном лишае и дерматите, грибке ступней и при других кожных заболеваниях.
Лишай у человека
При лишае кожа воспаляется и нарушается её пигментация, выпадают волосы, появляется зуд. Чаще всего данное заболевание возникает из-за инфекции, грибка или вируса. В группе риска находятся люди с ослабленным иммунитетом и дети. Если лишай у человека появился, надо идти к дерматологу. Лечение будет зависеть от вида лишая. В любом случае больного нужно изолировать, ведь многие виды лишая передаются при тесном контакте.
Лишай у детей
Летом и осенью погода теплая и влажная, в такое время года грибковые инфекции чувствуют себя наиболее комфортно, поэтому с огромной скоростью передаются от одного человека к другому. Заболевают чаще те, кто имеет слабый иммунитет. Если даже споры грибов попадут на кожу, не факт, что человек заболеет. Лимфоциты и защитные белки могут хорошо среагировать, и не позволить грибку прицепиться. Слабый иммунитет не способен защитить организм, поэтому грибки размножаются не только на поверхности кожи, но и в глубоких её слоях.
Грибы, как и всё живое, нуждаются в жидкости. Если на коже достаточно влаги, грибы прорастают и активно размножаются. При повышенном потоотделении расширяются потовые каналы, и увеличивается проницаемость кожи – создаются благоприятные условия для размножения грибов.
Лишай у детей возникает чаще, чем у взрослых, поскольку детский иммунитет намного слабее, к тому же дети постоянно контактируют с животными. Родители не успеют отвернуться, а ребенок уже схватил кошку у подъезда. Бродячие животные переносят на себе огромное количество инфекций, в том числе лишай.
Если лишай появился на голове, ребенка придется обрить наголо, в противном случае лечение окажется бесполезным. Это может создать психологический дискомфорт, ведь дети жестоки по отношению друг к другу – им только дай повод поиздеваться над тем, кто выглядит не так, как все. Поэтому ребенка до полного выздоровления лучше забрать из детского сада или школы, желательно до тех пор, пока хоть немного не отрастут волосы. Также надо постоянно говорить с ребенком об этом заболевании, чтобы он понял, что это не что-то постыдное, а обычный грибок, который может появиться у кого угодно.
Лишай у кошек
Стригущий лишай поражает кожу, шерсть и когти кошек. Данное инфекционное заболевание может у животного пройти без какого-либо лечения, но лучше все-таки помочь питомцу и ускорить этот процесс.
Грибки находятся не только на самом животном, но и на той территории, где оно ходит. Самое опасное – это то, что споры могут сохранять свою активность в течение двух лет.
Лишай у кошек может никак не проявляться некоторое время и о том, что он есть можно узнать только при проведении специальных тестов.
Лишаи у собак
Собака заражается лишаем при тесном контакте с носителем. Грибок не всегда проявляет себя сразу. Симптомов заболевания может не быть, а животное уже является носителем.
Лишаи у собак лечатся мазями и препаратами, которые нужно принимать внутрь. Для того чтобы составить схему лечения, надо показать животное ветеринару.
Лишай фото
1. Розовый лишай фото

2. Опоясывающий лишай фото

3. Отрубевидный лишай фото

4. Красный лишай фото

Похожие статьи:
Виды высыпаний
Дерматоз
Кожные заболевания
Мазь от сыпи
Фотодерматоз
sblpb.ru
инкубационный период, лечение :: SYL.ru
Кожные заболевания сегодня встречаются очень часто. Причем такие проблемы могут доставлять дискомфорт не только вам, но и вашим близким, так как являются инфекционными и заразными. Например, часто пациентов дерматолога интересует вопрос: передается ли лишай от человека к человеку?
Что это за болезнь?
 Данная патология является очень распространенной проблемой. Она представляет собой инфекционное поражение кожных покровов, которое может возникать на любой части тела. Чаще всего передается от животного к человеку. Переносчиками могут быть кошки и собаки.
Данная патология является очень распространенной проблемой. Она представляет собой инфекционное поражение кожных покровов, которое может возникать на любой части тела. Чаще всего передается от животного к человеку. Переносчиками могут быть кошки и собаки.Нужно учесть, что эта проблема доставляет не только неприятные физические ощущения, но и моральное неудовлетворение. Дело в том, что симптомы патологии видны очень явно и вызывают своеобразный страх у окружающих.
Если у вас появился лишай, заразный или нет, он зависит от типа заболевания.
Причины появления
 Теперь нужно выяснить, почему развивается эта болезнь. Существуют такие причины ее появления:
Теперь нужно выяснить, почему развивается эта болезнь. Существуют такие причины ее появления:— Существенное ослабление иммунитета.
— Наследственный фактор.
— Острые респираторные инфекции.
— Контакт с зараженным животным.
— Прием некоторых медикаментозных препаратов.
— Аллергическая реакция.
Причины появления проблемы могут быть разными. Передается ли лишай от человека к человеку, тоже следует знать, чтобы избежать заражения.
Симптоматика патологии
 Тут уже все зависит от типа болезни. Однако можно назвать некоторые общие признаки:
Тут уже все зависит от типа болезни. Однако можно назвать некоторые общие признаки:1. Неприятные пятна на коже, которые могут шелушиться.
2. Зуд и жжение в области поражения.
3. Пятна могут иметь строгие очертания с яркой каемкой по краям.
4. Выпадение волос в области поражения, если инфекция локализуется на голове.
В принципе, лишай, пятна которого могут иметь разные размеры, виден сразу. Поэтому особых технических приборов для его обнаружения не требуется.
Диагностика
 Если у вас появился лишай, симптомы помогут доктору правильно установить диагноз и определить тип заболевания. Тогда вы получите адекватное эффективное лечение. Диагностировать данную проблему не составляет труда.
Если у вас появился лишай, симптомы помогут доктору правильно установить диагноз и определить тип заболевания. Тогда вы получите адекватное эффективное лечение. Диагностировать данную проблему не составляет труда.Прежде всего, вас должен осмотреть врач-дерматолог. При этом он может применить лампу Вуда, которая позволяет убедиться в правильности диагноза. При надобности у пациента могут быть взяты пробы кожи, которые потом будут рассматриваться под микроскопом. В любом случае профессиональная консультация специалиста вам не повредит. Самолечением заниматься ни в коем случае нельзя. Неправильная терапия может помочь инфекции распространиться по коже еще больше.
Лишай: виды
 Передается ли лишай от человека к человеку, вы узнаете несколько позже. А сейчас вам предстоит рассмотреть классификацию представленной патологии. Виды заболевания могут быть разными. Соответственно, лечение тоже подбирается индивидуально. Есть такие виды лишая:
Передается ли лишай от человека к человеку, вы узнаете несколько позже. А сейчас вам предстоит рассмотреть классификацию представленной патологии. Виды заболевания могут быть разными. Соответственно, лечение тоже подбирается индивидуально. Есть такие виды лишая:— Розовый. Это самый распространенный тип патологии. Он характеризуется такими признаками: небольшие пятна, которые со временем становятся желтыми. Постепенно они распространяются по всему телу и становятся розовыми. Естественно, пациент в этом случае может почувствовать зуд. Иногда этот вид заболевания проходит самостоятельно, без применения терапии.
— Красный плоский. Он может проявляться в форме узелков, пузырей, красных колец, остроконечных образований.
— Стригущий. Этот тип патологии способен передаваться от больного человека к здоровому. Характеризуется он появлением красных и розовых пятен. Пораженная кожа начинает шелушиться. Часто локализуется патология на волосистой части головы.
— Опоясывающий. Он очень похож на ветрянку. При этом дополнительными признаками могут быть повышенная температура, увеличение лимфатических узлов.
— Отрубевидный. Он имеет хронический характер. Заболевание характеризуется темными пятнами, которые имеют очень яркие границы. Локализоваться они могут на шее, туловище, подмышках.
— Разноцветный. Это грибковое заболевание, которое поражает роговой слой эпидермиса.
К заразным видам относится стригущий, опоясывающий, розовый, отрубевидный лишай. Возможность передачи болезни особенно зависит от состояния иммунной системы человека.
Лишай (виды его мы уже рассмотрели) — это очень неприятная патология, которая требует немедленного вмешательства дерматолога.
Традиционное лечение
 Терапия направлена не только на снижение интенсивности симптомов, но и на уничтожение возбудителя. Естественно, прописывать все медикаментозные препараты должен врач. Именно он определяет, какой тип патологии присутствует именно у вас и какими лекарствами можно будет быстрее от нее избавиться. Итак, традиционная терапия предполагает применение таких препаратов:
Терапия направлена не только на снижение интенсивности симптомов, но и на уничтожение возбудителя. Естественно, прописывать все медикаментозные препараты должен врач. Именно он определяет, какой тип патологии присутствует именно у вас и какими лекарствами можно будет быстрее от нее избавиться. Итак, традиционная терапия предполагает применение таких препаратов:1. Противогрибковые мази: «Миконазол», «Ламизил», «Клотримазол».
2. Антигистаминные средства: «Тавегил».
3. Противовирусные препараты: «Ацикловир».
4. Обезболивающие лекарства и мази для устранения зуда: «Адвантан».
5. Поливитаминные комплексы для повышения иммунитета
Если вам был поставлен диагноз «лишай», лечение лучше проводить под наблюдением врача. Хотя терапия и не требует условий стационара.
Народное лечение
Тут уже можно назвать огромное количество различных средств, испытанных временем. Лишай, лечение народными средствами которого тоже может обеспечить хороший эффект, действительно боится некоторых трав. Вы можете применять такие рецепты:
1. Одну большую ложку измельченного чеснока смешайте со 100 г меда. Этим средством можно смазывать опоясывающий лишай.
2. Очень полезным считает отвар гречки. Причем использовать его можно при любом заболевании. Для приготовления нужно сварить 1 стакан крупы в двух стаканах воды.
3. Убрать лишай, симптомы которого порой просто раздражают, может дрожжевое тесто. Достаточно просто сделать из него лепешку и приложить ее к пораженному месту.
4. Сок ягод земляники или калины является отличным противогрибковым средством. Достаточно смазывать жидкостью кожу не менее двух раз в день.
5. На ночь к больному месту приложите примочку отвара из листьев лопуха. Делается он очень просто. Нужно просто на 15 минут залить сырье кипятком.
Естественно, старайтесь полноценно питаться, чтобы ваш иммунитет был крепким и смог быстро побороть болезнь.
Профилактика
Нужно сразу сказать, что данная патология является заразной. Подцепить ее вы можете только контактным путем: прикоснувшись к пораженной коже больного, взявшись за ручку в транспорте, использовав расческу или полотенце другого человека. Теперь вы знаете ответ на вопрос, передается ли лишай от человека к человеку.
Далее нужно подумать, как не допустить заражения. Ведь просто уберечь себя всегда лучше, чем потом лечиться. Для того чтобы не заразиться, соблюдайте такие меры профилактики:
— Не пользуйтесь чужими личными вещами.
— Соблюдайте правила личной гигиены.
— Не берите на руки больных и незнакомых животных.
— Ограничьте использование синтетической обуви и одежды, которая способствует повышенному потоотделению, а значит, создает идеальные условия для развития грибка.
— Повышайте свой иммунитет путем отказа от вредных привычек, составления режима питания, потребления полезных продуктов, содержащих витамины и минералы.
— После посещения общественных бань или саун старайтесь дополнительно вымыться дома с использованием антибактериального мыла. Естественно, все полотенца, постельные принадлежности, белье больного нужно обязательно кипятить.
При первых же признаках патологии постарайтесь обратиться к доктору. Если он диагностирует лишай, симптомы можно будет устранить гораздо быстрее на ранних стадиях развития заболевания. Будьте здоровы!
www.syl.ru
Как долго лечится лишай у человека, как понять что он проходит?
Лишай – это инфекционное дерматологическое заболевание кожного покрова человека. Как известно, кожа – это самый большой человеческий орган, который отвечает за защитные функции, нормализацию водного баланса организма и многое другое. Пренебрегая уходом за кожей, можно не только нанести косметический вред организму, но и повлечь нарушение работы органов и систем организма.
Лишай считается самым распространённым кожным заболеванием. Он проявляется в виде разнородовых пятен на теле человека. Некоторые виды лишая проходят самостоятельно, но другие требуют особого ухода и лечения на протяжении долгого времени. Неправильное и нецеленаправленное лечение может вызвать ряд тяжелых болезней, лечение которых отнимет много средств, сил и энергии. Поэтому необходимо знать, как отличить разные виды лишая, какое лечение необходимо, сколько нужно заниматься антилишайной терапией и в целом, сколько лечить лишай.
Продолжительность и методы лечения разных видов лишая
Существует несколько основных разновидностей лишая. Каждый из них требует уникального лечения с разными сроками выздоровления.
Простой белый лишай
Самый безвредный вид лишая у человека. Он проявляется в виде округлых пятен белого цвета, которые имеют слегка шелушащую структуру. Белый лишай в основном поражает людей в подростковом возрасте. Он не вызывает зуда, жжения и боли, поэтому единственный дискомфорт лишая носит косметологический характер.
Организм способен самостоятельно бороться с белым лишаем. Срок такого самооздоровления составляет пару месяцев. Если способствовать организму внешне, выздоровление ускорится.

В летний период достаточно мазать пораженные участки увлажняющим кремом. Зимой лечение дается немного сложнее, так как мороз вызывает дополнительное шелушение и воспаление лишайных пятен. Поэтому в холодное время года стоит обратиться за помощью к однопроцентной мази с гидрокортизоном. Такими методами о белом лишае можно будет забыть уже через месяц.
Розовый лишай (лишай Жабера)
Проявляется в виде розовых пятен, вызывающих неприятный зуд в пораженных участках.
Розовый лишай является вирусно-аллергическим заболеванием, что не несет особого вреда организму. Для лечения понадобятся витамины для повышения иммунитета и антигистаминные средства для снятия зуда. Срок выздоровления занимает от месяца до двух. Это зависит от общего состояния больного.

Следует знать, что розовый лишай может рецидивировать в первые 10-15 дней после выздоровления. Поэтому не стоит прекращать лечение по первым признакам проходимости. После того как пятна сошли, на коже не должно остаться никаких следов. Это свидетельствует о том, что организм преодолел розовый лишай.
Стригущий лишай
Вызывается двумя видами грибков – микроспория и трихофития. Проявляется в виде красных пятен, которые увеличиваются со временем. Стригущий лишай поражает кожу, волосяной покров и ногти. В момент воспаления заболевания в зонах растительности, в участке пятен обламываются волосы. При поражении ногтей, они начинают усиленно слоиться, крошиться и тускнеть.
Лечение стригущего лишая проводится с помощью таблеток, мазей, шампуней и прочего. Метод лечения зависит от стадии развития болезни, а также от индивидуальности больного. Средний срок выздоровления занимает период до трех месяцев.

И все же, как понять, что лишай проходит? Следует внимательно наблюдать за лишайными пятнами. В период выздоровления пятна перестают расти в размере, кожа начинает подсыхать, а корочки на пораженных участках отпадают. Также под ними образовывается молодая кожа, которая гораздо светлее обычной. В последнюю очередь отпадают выпуклые валики вокруг пятен. Также необходимо сдать скребок с пораженного лишаем участка кожи на анализ. Если он покажет, что живых грибков нет, значит стригущий лишай преодолён.
Пройти повторный осмотр нужно обязательно. Так как грибковые споры размножаются в течение нескольких месяцев. И даже если симптомы проходят, грибковые споры могут присутствовать на коже и рецидивировать в любое время.
Опоясывающий лишай
Появляется вследствие заражения герпесом зостер – это тот же вирус, который вызывает ветряную оспу. Можно сказать, что опоясывающий лишай проявляется только у взрослых. У детей он выражается под видом ветрянки.
К основным симптомам этого вида лишая относятся: озноб, температура, головные боли, а также появление чешущихся розовых пятен в зоне локализации нервных окончаний.

В период лечения лишая у человека используются противовирусные препараты, анальгетики и жаропонижающие. Ответ на вопрос как долго лечится опоясывающий лишай, не могут дать даже профессиональные медики. И причиной этому является степень развития, опоясывающего лишая, а также влияние внешних факторов и возрастных критериев. К примеру, у молодого организма наружные язвочки проходят уже через две недели без специального лечения. Более старший организм уже не может самостоятельно справиться с проблемой, поэтому прибегает к медицинской помощи. Такое лечение длится около десяти дней.
После лечения опоясывающего лишая больные жалуются на головную боль, которая остается в качестве побочного эффекта. Такая боль может сопровождать больного от месяца до года.
Красный плоский лишай
Характеризуется появлением красных зудящих папул с плоской поверхностью. По статистике красный лишай чаще поражает женщин в возрасте от сорока до шестидесяти лет. Также, сахарный диабет показывает на прямую предрасположенность к красному лишаю.
Он появляется в зонах изгибов рук и ног, на внутренней стороне бедер. Реже на слизистой оболочке, что способствует его проявлению в сочетании с другими язвеподобными заболеваниями. К примеру, язва, гастрит, цирроз и другие. Эта отличительная черта усложняет курс лечения. Поэтому о том, сколько лечится лишай в случае этой болезни утверждать невозможно. Нередким случаем является рецидив болезни в течение пяти лет, что свидетельствует о незаконченном курсе лечения.

В период лечения используются антибиотики, антигистаминные препараты, витамины, иммуномодуляторы и успокоительные средства.
Отрубевидный лишай
Вызывается грибком и поражает верхний слой эпидермиса. Он выступает на теле в виде желтых или коричневых пятен, из-за которых также получил название разноцветного лишая. Пятна сопровождаются легким зудом. Отрубевидный лишай может проявляться только в период гормональных сбоев и критичных снижениях иммунитета.

Для лечения необходимо пользоваться противогрибковыми препаратами. При легкой стадии заболевания и степени поражения кожного покрова от разноцветного лишая можно избавиться за неделю. Остальные сроки устанавливаются дерматологом при прохождении осмотра.
Для утверждения о полном выздоровлении, необходимо сдать соскоб пораженных участков на анализы. Если под микроскопом не присутствует живых клеток грибка, то болезнь прошла.
Также существует народный метод или проба Бальцера для простой диагностики отрубевидного лишая. Для этого понадобится обычный йод. Его следует нанести на ранки. Если цвет язвочек приобретает тёмно-коричневый цвет, то болезнь в стадии развития. Если цвет лишайных пятен становится желтоватым – болезнь проходит.
Мокнущий лишай или экзема
Вызвана вследствие внутренних патологий. Видимость на теле проявляется в наличии красных пятен с пузырьками, наполненными серозной или геморрагической жидкостью. Также в симптомных проявлениях отмечают отечность, покраснение кожи, трещины и шелушение. После прямого контакта с водой возникает усиленный зуд.

Лечение мокнущего лишая проходит с помощью гормональных и антигистаминных препаратов. Также используются подсушивающие и успокоительные мази для снятия зуда.
Такое лечение занимает очень долгое время. В период лечения необходимо соблюдать гипоаллергенную диету и уменьшить количество воздействия воды на ранки.
Чешуйчатый лишай или псориаз
Возникает при наличии внутренней предрасположенности организма к заболеванию. Проявляется в виде красных папул, покрытых белыми чешуями.
В курс лечения чешуйчатого лишая входят лишь методы снятия наружных симптомов, так как псориаз неизлечим и проявляется в течение всей жизни.
Важно, что псориаз может подстраиваться и вырабатывать иммунитет к методу лечения и его препаратов. Поэтому очень часто медики меняют технологии и лекарства для борьбы с псориазом.

Негативные последствия после самолечения
Многие люди лечат лишай самостоятельно с помощью информации в интернете и народных средств. Такой метод лечения неприемлем медиками. Так как для определения точного диагноза, необходимо пройти медицинское обследование и сдать необходимые анализы и скребки. Неправильный диагноз, а в следствии и неправильное лечение, может не только не излечить болезнь, но и изрядно навредить организму. Ведь для каждого вида лишая необходимо разное лечение. При этом препараты, которые помогут при одном виде лишая, при другом осложнят положение. А в некоторых ситуациях каждый день дорог. Поэтому при появлении любых симптомов лишая, необходимо обратиться к дерматологу для установления точного диагноза и определения курса лечения.
Следует знать, что некоторые разновидности лишаев способны вызывать вирус, который находится в организме человека долгие годы и снова проявляется в благоприятной среде. К таким видам относится розовый и стригущий лишай. Другие же способны десятилетиями находится в теле. К примеру, если не вылечить белый лишай в детском возрасте, он приобретает форму хронического заболевания и будет рецидивировать в моменты иммунной слабости организма.
dermatologtut.ru
заразные и незаразные формы, пути передачи заболевания
Говоря о том, как передается лишай от человека к человеку, стоит помнить также, что это заболевание может передаться человеку от животных. Возможность заражения во многом зависит от состояния иммунитета человека, а также от разновидности лишая. Как правило, передача осуществляется методом прямого контакта, через общие предметы быта или личной гигиены. Прежде чем разобраться, заразен ли лишай от человека к человеку, следует понять, что такое лишай.
Что вызывает лишай
Лишай представляет собой инфекционное дерматологическое заболевание, поражающее верхние слои эпидермиса. В качестве характерных признаков лишая выступают зуд, шелушение кожи и нарушение пигментации. Возбудители заболевания — микроорганизмы. Некоторые виды этого заболевания имеют вирусную природу. К таким заболеваниям можно отнести опоясывающий и розовый лишай. Чаще всего эти виды развиваются на фоне слабых защитных функций организма. Другие же формы болезни являются следствием поражения грибком, например, стригущий лишай.
Часто лишай путают с демодекозом, возбудителем которого является подкожный клещ. Некоторые виды также могут быть похожи на фурункулез или проявления аллергии. Поэтому при первых симптомах необходимо пройти обследование у специалиста.
Заразен ли лишай
Заразность заболевания определяется по его виду и состоянию иммунитета. В медицине это заболевание относят к условно-передающимся.
К заразным формам относятся несколько видов, например, опоясывающий, стригущий, розовый лишай передается от человека к человеку. Передача заболевания осуществляется следующим путем:
- От больного к здоровому посредством прямого контактирования или использования личных и бытовых предметов.
- От животного к здоровому человеку через контакт с ним.
Один из первых способов — от больного человека к здоровому. При этом заражение происходит при использовании зараженных предметов личной гигиены, вещей, постельного белья или полотенца. Передача инфекции возможна через прямой контакт с больным:
- Рукопожатие.
- Прикосновение.
- Поцелуй.
Заразиться также можно в общественном транспорте, дотронувшись до поручней, или через дверные ручки в общественных местах. Именно таким образом передается розовый лишай. Но может ли передаваться это заболевание от человека к человеку воздушно-капельным путём? На этот вопрос следует однозначный отрицательный ответ.
Контактному способу заражения чаще всего подвергаются люди, которые имеют ослабленный иммунитет. Лишаи грибковой породы легко могут передаваться во влажной среде, например, в бане, сауне или бассейне. Такими формами заболевания можно также легко заразиться во время посещения песчаного пляжа.
 От собаки или кошки можно заразиться стригущим лишаем. Этот вид заболевания считается самым высококонтагиозным. Он нередко отмечается у детей, которые имеют частые контакты с бездомными животными. Чтобы избежать заражения стригущим лишаем, необходимо оградить своих детей от уличных бродячих собак. У больных животных наблюдаются участки облысения на теле. Именно поэтому форма называется стригущей. Ни в коем случае до таких участков кожи нельзя дотрагиваться, так как это несет большую опасность заразиться.
От собаки или кошки можно заразиться стригущим лишаем. Этот вид заболевания считается самым высококонтагиозным. Он нередко отмечается у детей, которые имеют частые контакты с бездомными животными. Чтобы избежать заражения стригущим лишаем, необходимо оградить своих детей от уличных бродячих собак. У больных животных наблюдаются участки облысения на теле. Именно поэтому форма называется стригущей. Ни в коем случае до таких участков кожи нельзя дотрагиваться, так как это несет большую опасность заразиться.
Некоторые формы могут передаваться и в обратном направлении, например, от человека к кошке. Если больной будет контактировать со здоровым животным, то оно тоже может заразиться этим заболеванием. Чаще всего таким методом передается стригущий лишай. Как уже говорилось выше, он является характерным для животных, может легко передаваться как от животного к человеку, так и наоборот.
Также стоит отметить, что даже переболевшая кошка или собака может быть потенциальным источником этого заболевания. Дело в том, что в шерсти могут остаться микроспоры, особенно если у животного крепкий иммунитет. При одиночном контакте чаще всего заражения не происходит, но в таких случаях всё же лучше после контакта с животным тщательно мыть руки с мылом.
Виды заболевания
Самыми распространенными видами лишая являются следующие:
- Розовый.
- Стригущий.
- Отрубевидный.
- Опоясывающий.
Стригущий
 Эта форма является одной из самых распространённых. В качестве возбудителя выступает грибок, в зависимости от вида которого выделяют две формы заболевания — микроспория или трихофития.
Эта форма является одной из самых распространённых. В качестве возбудителя выступает грибок, в зависимости от вида которого выделяют две формы заболевания — микроспория или трихофития.
Трихофитией заражаются люди во время контакта с больным. Микроспория же чаще всего передается от уличных бродячих животных, поэтому заражению чаще всего подвергаются маленькие дети, которые могут поиграть с собакой или кошкой на улице.
Стригущий лишай можно опознать по следующим симптомам:
- Появляются очаги покраснения с неровными краями, середина шелушится, окантовка состоит из маленьких пузырьков.
- В центре образования могут выпадать волоски.
- При локализации на голове могут появляться участки облысения.
Здоровым людям не рекомендуется:
- Касаться очагов воспаления больного.
- Иметь тесный контакт с больным.
- Носить одежду больного.
- Пользоваться предметами личной гигиены больного и спать с ним в одной постели.
- Контактировать с уличными и домашними больными животными, особенно при образовании у них очагов облысения.
Розовый
Для этого вида лишая характерны небольшие овальные или круглые слегка шелушащиеся пятна. Как правило, они коричневатого или розоватого оттенка. Природа заболевания носит инфекционно-аллергический характер, основным возбудителем является вирус. Точная причина заболевания до сих пор неизвестна. Некоторые специалисты полагают, что возбудителем является вирус герпеса. Кроме этого, не имеется также точных данных о том, может ли передаваться розовый лишай от больного к здоровому. Практика показывает, что он является менее заразным по сравнению с другими формами заболевания.
Довольно редко встречались случаи, где в семье одновременно болело несколько человек. Если же это всё-таки случалось, то специалисты отмечали, что причиной тому являлась наследственная предрасположенность. Решающим фактором здесь будет являться состояние нервной системы и иммунитета. У чересчур мнительных и возбудимых людей симптомы болезни часто усиливаются. Но всё же некоторые врачи считают, что заразиться розовым лишаем можно путем использования некоторых вещей больного:
- Полотенца.
- Расчёски.
- Посуда.
- Одежда.
- Постельное белье.
- Телефон, а также другие личные предметы.
Опоясывающий
Основным возбудителем этого заболевания является вирус герпеса 3 типа, который также провоцирует у людей ветряную оспу. Как правило, болезнь распространяется чаще всего по межреберным нервным волокнам, провоцируя при этом сильную боль, особенно в областях будущих очагов.
 Симптомы заболевания также сопровождаются появлением высыпаний на теле в виде мелких пузырьков, наполненных жидкостью. Внешне эти высыпания очень напоминают герпес на губах. Спустя некоторое время пузырьки начинают вскрываться, жидкость из них вытекает, а после подсыхания на месте образований образуется корка. Часто опоясывающий лишай сопровождается повышенной температурой тела. В качестве осложнения выступает невралгия.
Симптомы заболевания также сопровождаются появлением высыпаний на теле в виде мелких пузырьков, наполненных жидкостью. Внешне эти высыпания очень напоминают герпес на губах. Спустя некоторое время пузырьки начинают вскрываться, жидкость из них вытекает, а после подсыхания на месте образований образуется корка. Часто опоясывающий лишай сопровождается повышенной температурой тела. В качестве осложнения выступает невралгия.
Эта форма может передаваться во время контакта больного со здоровым, но тут имеется одно условие. Заражение может происходить только во время высыпаний. Если у больного человека уже образовались корочки на высыпаниях, то он является неопасным для окружающих. Минимальные шансы заражения также имеют те люди, которые уже переболели ветряной оспой. В целом опоясывающий лишай развивается на фоне ослабленного иммунитета. Он не может передаваться воздушно-капельным путём. Как правило, заражение происходит лишь посредством:
- Использования с больным одних и тех же предметов личной гигиены.
- Тесного контакта с больным.
Отрубевидный
Возбудителем этой формы являются дрожжеподобные грибки, которые размножаются в роговом слое эпидермиса. При этом на различных участках тела образуются разные по цвету и размеру пятна. Они могут быть розовыми, желтыми, коричневыми или зеленоватыми. Эта форма заболевания может длиться годами. Чаще всего отрубевидный лишай провоцируется нарушением обмена веществ или сопровождает другие заболевания, например:
- Туберкулез.
- Сахарный диабет.
- Себорейный диатез.
- Гипергидроз.
- Иммунодефицитные состояния.
- Вегетососудистая дистония.
Специалисты утверждают, что эта форма лишая не является заразной, так как дрожжеподобный грибок является частью нормальной микрофлоры кожного покрова. Но всё же не рекомендуется использовать с больным одни и те же предметы. При единичном контакте вероятность заразиться отрубевидным лишаем сводится к минимуму. Чаще всего этим заболеванием болеют супруги и люди, которые пользовались одеждой больного.
Профилактические меры
В качестве профилактики заражения лишаем необходимо соблюдать всего лишь несколько простых правил. Главное из них заключается в ограничении контакта с больными людьми или питомцами. Детям при этом рекомендуется не прикасаться к посторонним животным. Домашнему любимцу желательно делать прививки. Кроме этого, необходимо также соблюдать и другие профилактические нормы:
- Использовать только личные предметы гигиены.
- Не надевать чужую одежду.
- Не мыть всё тело антибактериальным мылом.
- Часто протирать руки антибактериальными салфетками или мыть их.
- Укреплять свой иммунитет методом правильного питания и физической активности.
- Регулярно делать влажную уборку в помещении и проветривать его.
- Проводить дезинфекцию помещения, где находится больной.
При первых же симптомах патологии необходимо обратиться к специалисту. Если заболевание будет подтверждено, то симптомы необходимо устранить как можно быстрее на первоначальном пути развития лишая.
kozha.me